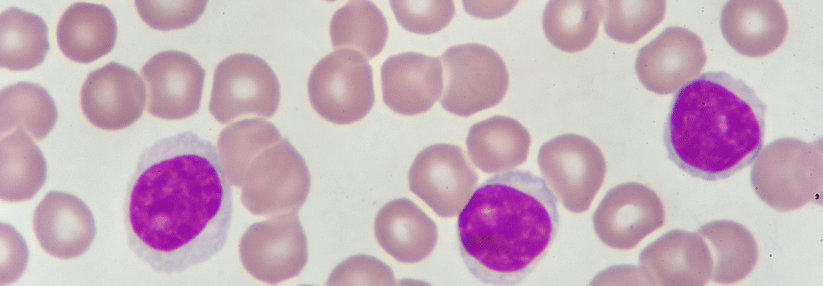

BTK und BCL2 Es gibt keinen eindeutigen Sieger in der CLL-Erstlinie
 Welcher Hemmer gewinnt wohl den Vergleich?
© Fotos: ZinetroN – stock.adobe.com, Science Photo Library/Molekuul, Science Photo Library/Oto, Evan
Welcher Hemmer gewinnt wohl den Vergleich?
© Fotos: ZinetroN – stock.adobe.com, Science Photo Library/Molekuul, Science Photo Library/Oto, Evan
Die Etablierung neuer zielgerichteter Substanzen trug maßgeblich dazu bei, die Prognose von CLL-Patient:innen zu verbessern. Da sich die meisten Erkrankten für eine Chemoimmuntherapie nicht eignen, sehen sich Ärzt:innen häufig mit der Frage nach einer geeigneten initialen zielgerichteten Behandlung konfrontiert: Setzt man lieber dauerhaft einen BTK-Inhibitor, z.B. Ibrutinib, ein oder ist man möglicherweise mit einer zeitlich begrenzten Kombination aus dem BCL2-Hemmer Venetoclax und einem CD20-Antikörper wie Rituximab oder Obinutuzumab besser beraten? Head-to-Head-Vergleiche der beiden Strategien gibt es bisher nicht.
Pro BCL2-Inhibitoren
Tiefe Remissionen und selten Resistenzbildung
…
Bitte geben Sie Ihren Benutzernamen und Ihr Passwort ein, um sich an der Website anzumelden.